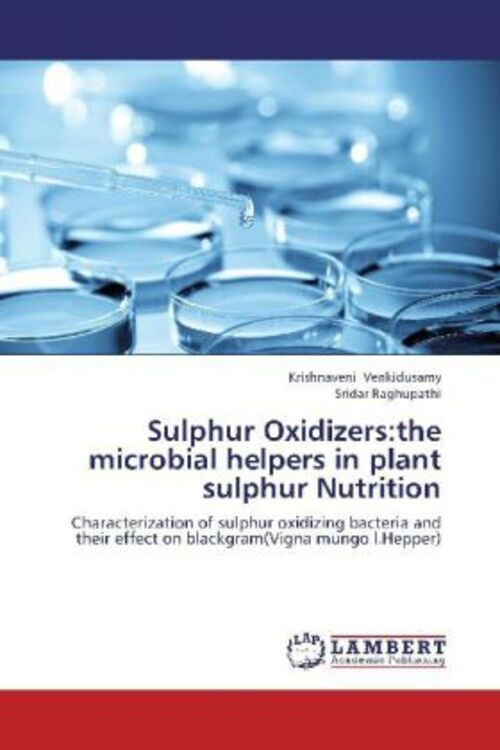
Krishnaveni Venkidusamy (u. A.) | Sulphur Oxidizers:the Microbial

Louise Ackers (u. A.) | Anti-microbial Resistance In Global
Finden Sie Louise Ackers (u. A.) | Anti-microbial Resistance In Global bei eBay in der Kategorie Bücher & Zeitschriften:Büche...
Finde die besten Angebote
Bester Preis

ebay
Versand: 2,95 €
Lieferzeit: 4-6 Werktage
Versand: 2,95 € | Lieferzeit: 4-6 Werktage
Ähnliche Produkte
Produktdetails
Finden Sie Louise Ackers (u. A.) | Anti-microbial Resistance In Global bei eBay in der Kategorie Bücher & Zeitschriften:Bücher.
Informationen
Lieferzeit:4-6 Werktage
Marke:Springer International Publishing